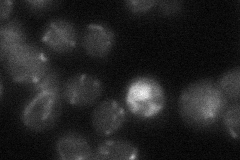
YDR219C
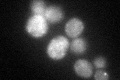
YDR219C

View description
Mitochondria-associated F-box protein involved in maintenance of normal mitochondrial morphology; interacts with Skp1p through the F-box motif; preferentially localizes to the mother cell during budding
Localization:
Intensity:
Fold change:
Significance:
-
C’ GFP library in SD

mitochondria26.18 -
N' NOP1pr-GFP in SD

mitochondria38.1081 -
N' TEF2pr-mCherry in SD

mitochondria24.8375 -
N' NATIVEpr-GFP in SD
punctate,mitochondria22.4435 -
N' TEF2pr-VC and Cyto-VN in SD

below threshold27.5683 -
C’ GFP library in SD+DTT
mitochondria27.731.05No -
C’ GFP library in SD+H2O2

mitochondria27.241.04No -
C’ GFP library in Starvation Media

mitochondria17.980.68Yes -
C’ GFP library on the background of Pup2-DaMP

mitochondria -
C’ GFP library on the background of CCT mutant

mitochondria29.69961.13405No
